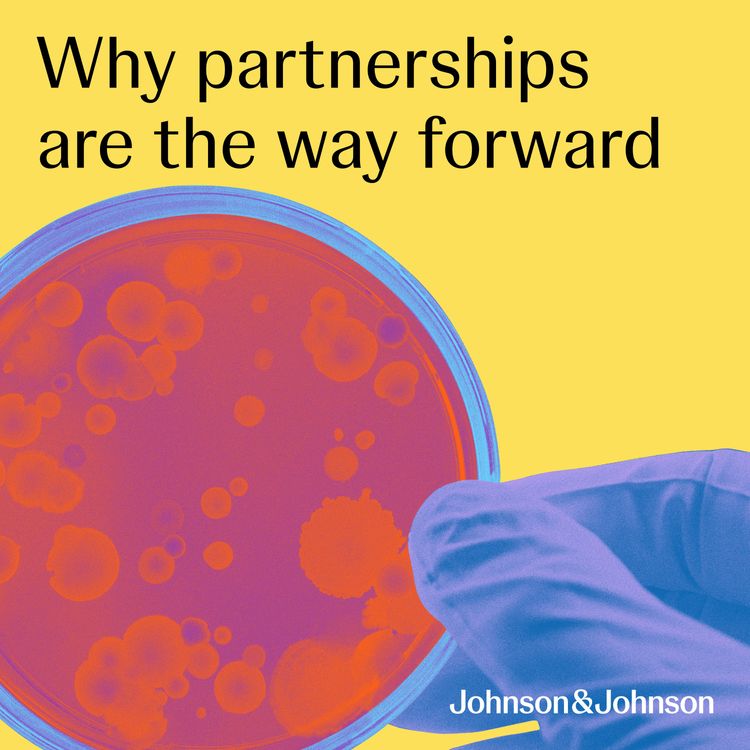
cover art for Why partnerships are the way forward

Share
Transforming Health
Why partnerships are the way forward
Season 2, Ep. 1
•
In this episode, we explore the current pressure on Europe’s healthcare resources and how partnerships can help reduce inefficiencies and take us forward – with examples from the Nordic region.
As the need for value-based healthcare becomes more apparent, we speak to Sofia Iqbal, Real-World Evidence Strategic Partnerships Lead for EMEA, about how collaboration identifies innovative solutions that could ultimately improve patient care.
This recording was organised and funded by Johnson & Johnson
October 2024
CP-478884 | CP-478875
More episodes
View all episodes

1. The power of investing in health
23:04||Season 4, Ep. 1In this episode, we explore why health should be seen as an investment, that delivers positive returns for individuals, economies and society as a whole.Hosted by Nicole Raleigh of Pharmaphorum, the conversation brings together perspectives from J&J Innovative Medicine and economic research institute, WifOR to unpack the social and economic value of health, the consequences of short-term thinking and why long-term, sustainable investment in health is essential for future prosperity. This recording was organised and funded by Johnson & Johnson. March 2026 CP-562493
3. Precision medicine in cancer: A new era
23:32||Season 3, Ep. 3This episode focuses on precision medicine in cancer – why it’s considered so revolutionary, and how we can work together to make it more accessible to every patient.Our experts offer their perspectives on the challenges within the treatment pathway and infrastructure, as well as potential solutions that could help increase access and uptake. This recording was organised and funded by Johnson & Johnson.October 2025CP-530938
2. Endoscopy in IBD: Going beyond diagnosis
21:07||Season 3, Ep. 2In this episode, our experts shine a light on the benefits of endoscopy in the long-term management of inflammatory bowel disease (IBD). Despite the valuable role of endoscopy, there are still barriers to its adoption in care pathways. We explore why that is, and how we need to shift perceptions and work collaboratively to improve long-term patient outcomes in IBD. This recording was organised and funded by Johnson & Johnson.September 2025CP-530931
1. Shared decision-making in multiple myeloma
24:35||Season 3, Ep. 1In this episode, we talk about the importance of shared decision-making in helping patients achieve a “life of possibility”, especially in complex illnesses like multiple myeloma. Our experts discuss the barriers that prevent patients and HCPs from being equal partners, how shared decision-making leads to better decision-making, and the critical role of advocacy groups in empowering patients to have a greater say in their treatment pathway.This recording was organised and funded by Johnson & Johnson August 2025CP-530923 | CP-530918
3. How we can overcome patient access hurdles
21:17||Season 2, Ep. 3In the final episode of Season 2, we look at the future of healthcare in Central Europe and the Baltics, a diverse region that covers almost one third of EU countries. Tuba Atahan, Managing Director, and Laura Saar, Market Access Director, for Central Europe and Baltics delve into the current barriers to healthcare access in the region – such as the growing disparity in multiple myeloma care – and discuss innovative solutions that will help close the gap. This recording was organised and funded by Johnson & Johnson November 2024CP-485355 | CP-485428
2. How collaboration supports future healthcare workers
15:02||Season 2, Ep. 2In this episode, we find out how the healthcare industry and academic institutions are working together to find solutions to a decreasing healthcare workforce. Giuseppe Pompilio, Director of Market Access, Johnson & Johnson, Italy, joins us to discuss the results of a recent academic partnership and the new healthcare roles that are key to progressing patient care. This recording was organised and funded by Johnson & Johnson October 2024CP-479290 | CP-479287
3. How R&D pushes the boundaries
13:34||Season 1, Ep. 3In this episode, we’re speaking with an expert in Switzerland to better understand the role of research and development, manufacturing, and supply chain in creating an ecosystem that fosters healthcare innovation.We also discuss some potential real-world solutions and explore how talented people, in the right environment, make Switzerland such a unique hub for science, innovation and excellence in Europe.This recording was organised and funded by Johnson & Johnson July 2024CP-463603
2. When delivering medicine is time critical
25:10||Season 1, Ep. 2In this episode, we’re looking at the unique approach France has taken to try and get new and innovative treatments to patients faster, and what other national health bodies could learn from this process.Joining us is an expert in market access and health policy, who has been at the forefront of recent regulatory changes in France and brings with her a wealth of knowledge from a career spanning three decades in pharmaceuticals.This recording was organised and funded by Johnson & Johnson June 2024 CP-460651